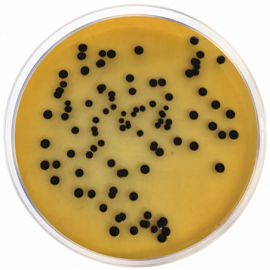

SS (Salmonella Shigella) Agar
Principles and uses
Salmonella Shigella Agar (SS Agar) is a selective and differential medium widely used in sanitary bacteriology to isolate Salmonella and Shigella from feces, urine, and fresh and canned foods.
Due to its strong inhibitory power, a heavy inoculum can be used in the SS agar. It must also be streaked in parallel, in less selective media such as Deoxycholate Agar, MacConkey Agar, Methylene Blue Eosin Agar (EMB), XLD Agar and Enteric Hektoen Agar , to increase the probability of detection when the population of microorganisms is scarce.
Beef extract and peptone mixture provide nitrogen, vitamins, minerals and amino acids essential for growth. Lactose is the fermentable carbohydrate providing carbon and energy. Bile salts mixture, sodium citrate and brilliant green inhibit Gram-positive bacteria, most coliform bacteria and swarming
Proteus spp., while allowing Salmonella spp to grow. Neutral red is the pH indicator. Sodium thiosulfate and ferric citrate allow the detection of the H2S producing bacteria.
Non-lactose fermenting bacteria (supposed pathogens, such as Shigella and the majority of salmonellae) produce clear colonies, transparent or colorless, while coliforms like E. coli are sufficiently inhibited, and form small colonies that vary from pink to red in color. Enterobacter and Klebsiella bacteria will produce larger colonies than E.coli, mucoid, pale and opaque cream to pink in colour. Colonies from Proteus and some strains of Salmonella will present black centers and a clear halo.
This formulation, highly selective, is not recommended for the primary isolation of Shigella. Some Shigella spp. may be inhibited
Preparation
Suspend 60 grams of the medium in one liter of distilled water. Mix well until a homogeneous suspension is obtained. Heat with frequent agitation and boil for one minute until complete disolution. DO NOT AUTOCLAVE. Cool to 45-50 °C and distribute in Petri dishes.